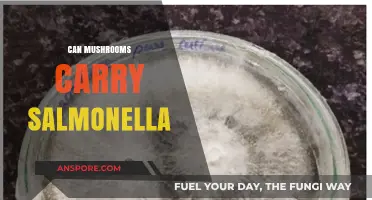
Can Mushrooms Carry Salmonella? Unveiling the Truth About Food Safety

Mushrooms, while celebrated for their nutritional benefits and culinary versatility, have also been scrutinized for their potential to cause adverse reactions in some individuals. One question that occasionally arises is whether mushrooms can trigger bladder spasms, a condition characterized by sudden, involuntary contractions of the bladder muscles, often leading to urgency, frequency, or discomfort. While mushrooms are generally considered safe for consumption, certain varieties, particularly wild mushrooms, contain compounds that may irritate the urinary system or interact with individual sensitivities. Additionally, some people with pre-existing conditions, such as interstitial cystitis or urinary tract infections, may experience exacerbated symptoms after consuming mushrooms. However, scientific evidence directly linking mushrooms to bladder spasms remains limited, and reactions are likely rare and dependent on factors such as mushroom type, preparation, and individual tolerance.
| Characteristics | Values |
|---|---|
| Direct Causation | No direct scientific evidence linking mushrooms to bladder spasms |
| Potential Triggers | Some individuals may be sensitive to certain mushroom compounds (e.g., lectins, oxalates) that could theoretically irritate the bladder |
| Allergic Reactions | Rare cases of mushroom allergies may cause urinary symptoms, including spasms, as part of a systemic reaction |
| Individual Sensitivity | Varies; some people might experience bladder irritation after consuming mushrooms, while others do not |
| Common Culprits | No specific mushroom species consistently linked to bladder spasms |
| Underlying Conditions | Individuals with interstitial cystitis or other bladder disorders might be more susceptible to irritation from dietary triggers, including mushrooms |
| Scientific Studies | Limited research specifically investigating mushrooms and bladder spasms |
| Anecdotal Reports | Some individuals report bladder discomfort after eating mushrooms, but these are not substantiated by clinical studies |
| Dietary Considerations | Mushrooms are generally considered bladder-friendly in most diets, but moderation is advised for those with sensitivities |
| Medical Advice | Consult a healthcare professional if you suspect mushrooms or any food is causing bladder spasms |
Explore related products
$8.99 $10.58
What You'll Learn

Types of Mushrooms Linked to Bladder Issues
Certain mushrooms, particularly those containing high levels of oxalates, have been linked to bladder issues, including spasms and irritation. Oxalates are naturally occurring compounds that can crystallize in the urinary tract, potentially leading to discomfort or more severe conditions like kidney stones. For instance, mushrooms such as shiitake and morel are known to contain moderate to high levels of oxalates. Individuals with a history of urinary tract issues or those on a low-oxalate diet should monitor their intake of these varieties. While not all mushrooms cause problems, awareness of their oxalate content is crucial for managing bladder health.
Another category of mushrooms to approach with caution is those with psilocybin, often referred to as "magic mushrooms." While primarily known for their psychoactive effects, psilocybin mushrooms can cause physical side effects, including increased urinary frequency and bladder discomfort in some users. These symptoms are typically temporary and dose-dependent, with higher doses (e.g., 2-3 grams dried mushrooms) more likely to induce such reactions. It’s essential to note that these effects are not universal and vary based on individual tolerance and metabolism. If bladder spasms occur after consumption, hydration and avoiding further intake are recommended.
Chanterelle mushrooms, prized for their fruity flavor, are generally considered safe but have been anecdotally linked to digestive disturbances in sensitive individuals. While not directly tied to bladder spasms, gastrointestinal discomfort can indirectly affect bladder function. For example, bloating or cramping may alter pelvic pressure, potentially triggering spasms in those predisposed to such issues. If you suspect chanterelles are causing problems, start with small portions (e.g., 50 grams per serving) and observe your body’s response before increasing intake.
Lastly, portobello mushrooms, a common variety in many diets, have been associated with histamine intolerance in some individuals. Histamine buildup can lead to symptoms like itching, headaches, and, in rare cases, urinary urgency or discomfort. While not a direct cause of bladder spasms, histamine-related reactions can exacerbate underlying bladder conditions. If you experience symptoms after consuming portobellos, consider limiting intake or opting for low-histamine alternatives like button mushrooms. Always consult a healthcare provider if symptoms persist or worsen.
Exploring Krautrock's Psychedelic Roots: Can Mushrooms Inspire Cosmic Soundscapes?
You may want to see also

Symptoms of Mushroom-Induced Bladder Spasms
Mushroom-induced bladder spasms, though rare, can manifest with distinct symptoms that warrant attention. These spasms occur when certain mushrooms, particularly those containing toxins like muscarine or ibotenic acid, stimulate the bladder’s smooth muscles. The onset of symptoms typically follows ingestion, with timing dependent on the mushroom species and dosage. For instance, *Clitocybe* species, known as "sweaty mushrooms," can cause symptoms within 15–30 minutes due to their high muscarine content. Recognizing these symptoms early is crucial for timely intervention.
Symptoms often begin with a sudden, overwhelming urge to urinate, even if the bladder is not full. This is accompanied by frequent urination and discomfort during voiding. In severe cases, individuals may experience incontinence or a burning sensation while urinating. These urinary symptoms are part of a broader cholinergic syndrome, which includes sweating, salivation, and gastrointestinal distress. The intensity of symptoms correlates with the amount consumed; as little as 50 grams of certain mushrooms can trigger noticeable effects in adults, while smaller quantities may affect children more severely.
Distinguishing mushroom-induced bladder spasms from other urinary conditions requires careful observation. Unlike urinary tract infections (UTIs), which often present with fever and cloudy urine, mushroom toxicity lacks systemic infection markers. Similarly, overactive bladder (OAB) symptoms are chronic and unrelated to recent ingestion of substances. A key differentiator is the rapid onset and resolution of symptoms after mushroom consumption, typically subsiding within 6–24 hours with proper treatment.
If symptoms arise, immediate steps should be taken to manage discomfort. Drinking water can help dilute toxins, but medical attention is essential for severe cases. Antimuscarinic drugs like atropine are often administered to counteract cholinergic effects. Practical tips include avoiding wild mushroom foraging without expert guidance and educating children about the dangers of consuming unknown fungi. Awareness and prompt action are vital to mitigating the risks of mushroom-induced bladder spasms.
Magic Mushrooms and Mortality: Debunking Myths About Fatal Risks
You may want to see also

Mechanisms Behind Mushroom-Related Spasms
Mushrooms, often celebrated for their nutritional benefits, can sometimes trigger unexpected reactions, including bladder spasms. These spasms, characterized by sudden, involuntary contractions of the bladder muscles, can be both uncomfortable and puzzling. While not all mushrooms are culprits, certain varieties contain compounds that may irritate the urinary system or interact with neurotransmitters, leading to spasms. Understanding the mechanisms behind these reactions is crucial for anyone experiencing this issue.
One key mechanism involves the presence of chitin, a fibrous substance found in mushroom cell walls. Unlike plant fibers, chitin is harder for the human digestive system to break down, potentially leading to gastrointestinal irritation. This irritation can trigger a systemic inflammatory response, affecting nearby organs like the bladder. For individuals with sensitive bladders or pre-existing conditions such as interstitial cystitis, even small amounts of chitin can exacerbate spasms. Limiting mushroom intake or opting for well-cooked varieties, which break down chitin more effectively, may help mitigate this risk.
Another factor is the role of mushroom-derived compounds like lectins and oxalates. Lectins, proteins found in some mushrooms, can bind to cells in the urinary tract, causing irritation and inflammation. Oxalates, naturally occurring substances in many mushrooms, can crystallize in the urinary system, leading to discomfort and spasms. Individuals prone to kidney stones or oxalate sensitivity should monitor their mushroom consumption, especially of varieties like shiitake or portobello, which are higher in these compounds. Staying hydrated and pairing mushrooms with calcium-rich foods can help reduce oxalate absorption.
Neurological interactions also play a role in mushroom-related bladder spasms. Certain mushrooms contain compounds like psilocybin or muscarine, which affect the central nervous system. Muscarine, for instance, mimics the neurotransmitter acetylcholine, leading to overstimulation of the bladder muscles. While this is more commonly associated with specific species like *Clitocybe dealbata*, accidental ingestion of such mushrooms can cause severe spasms. Foraging enthusiasts should exercise caution and accurately identify mushrooms before consumption to avoid such risks.
Finally, individual sensitivity and dosage are critical factors. Some people may experience spasms after consuming even small amounts of mushrooms, while others tolerate larger quantities without issue. A practical tip is to start with a minimal serving (e.g., 50 grams) and observe the body’s response before increasing intake. Keeping a food diary can help identify specific mushroom types or preparations that trigger spasms. For those with recurring issues, consulting a healthcare provider or dietitian is advisable to rule out underlying conditions.
Enhancing THC Effects: Exploring Mushrooms' Potential Role in Cannabis Synergy
You may want to see also
Explore related products

Prevention and Safe Mushroom Consumption
Mushrooms, while celebrated for their nutritional benefits and culinary versatility, can sometimes trigger adverse reactions, including bladder spasms in sensitive individuals. Prevention hinges on understanding which varieties are more likely to cause issues and how to prepare them safely. For instance, certain wild mushrooms contain compounds like muscarine, which can stimulate the bladder and lead to spasms. Cultivated varieties like button, shiitake, and oyster mushrooms are generally safer, but even these should be consumed in moderation, especially for those with a history of urinary sensitivity.
To minimize risks, start by sourcing mushrooms from reputable suppliers to avoid accidental ingestion of toxic or misidentified species. Wild foraging, while appealing, requires expert knowledge—a single mistake can have severe consequences. For example, the Amanita genus contains species that resemble edible varieties but are highly toxic. Always cook mushrooms thoroughly, as raw or undercooked mushrooms may retain compounds that irritate the bladder. Heat breaks down these substances, making them safer for consumption.
Dosage matters, particularly for dried mushrooms, which are more concentrated. A safe starting point is 1–2 grams of dried mushrooms per serving, gradually increasing based on tolerance. For fresh mushrooms, limit intake to 1–2 cups per meal. Individuals over 65 or with pre-existing bladder conditions should consult a healthcare provider before incorporating mushrooms into their diet. Hydration is key—drinking water alongside mushroom consumption can help dilute any irritants and support bladder health.
Pairing mushrooms with bladder-soothing foods can further reduce risks. Incorporate ingredients like pumpkin seeds, rich in magnesium, which relaxes bladder muscles, or parsley, a natural diuretic that promotes urinary flow. Avoid combining mushrooms with alcohol or caffeine, as these can exacerbate bladder irritation. Lastly, monitor your body’s response after consumption. If spasms occur, discontinue use and consider an over-the-counter antispasmodic medication under medical guidance.
In summary, safe mushroom consumption requires awareness, preparation, and moderation. By choosing the right varieties, cooking them properly, and pairing them with supportive foods, you can enjoy their benefits while minimizing the risk of bladder spasms. Always prioritize caution, especially when experimenting with new types or quantities, and seek professional advice if uncertainties arise.
Can Tainted Mushrooms Transmit Hepatitis B? Unraveling the Risks
You may want to see also

Medical Treatment for Mushroom-Caused Spasms
Mushroom-induced bladder spasms, though rare, can be distressing and require prompt medical attention. Treatment typically begins with identifying and discontinuing exposure to the causative mushroom species, such as *Clitocybe acromelalga* or *Inocybe* spp., which are known to contain toxins like muscarine or acromelic acids. Once identified, the focus shifts to managing symptoms and preventing complications. Antimuscarinic medications, such as oxybutynin or tolterodine, are often prescribed to inhibit bladder muscle contractions and alleviate spasms. These medications work by blocking muscarinic receptors in the bladder, reducing overactivity. Dosage varies by age and severity; adults may start with 5 mg of oxybutynin twice daily, while children’s doses are weight-based, typically 0.05–0.1 mg/kg/day.
Hydration plays a critical role in treatment, as it helps dilute toxins and supports kidney function. Patients are advised to drink at least 2–3 liters of water daily, unless contraindicated by other conditions. Intravenous fluids may be administered in severe cases to ensure adequate hydration and toxin clearance. Pain management is another key aspect; mild to moderate discomfort can be addressed with over-the-counter analgesics like acetaminophen, while severe pain may require opioids under medical supervision. It’s essential to avoid nonsteroidal anti-inflammatory drugs (NSAIDs) if kidney function is compromised, as they can exacerbate toxicity.
In cases where mushroom ingestion is recent, gastrointestinal decontamination may be considered. Activated charcoal, administered within 1–2 hours of ingestion, can bind toxins in the gut and reduce absorption. The typical dose is 50–100 grams for adults and 25–50 grams for children, mixed with water. However, this intervention is less effective for toxins that cause delayed symptoms, such as acromelic acids. Monitoring for complications, such as electrolyte imbalances or renal dysfunction, is crucial. Blood tests and urinalysis may be performed to assess kidney health and guide treatment adjustments.
Prevention is paramount, as mushroom-induced bladder spasms are entirely avoidable. Educating individuals about the risks of consuming wild mushrooms, especially those with unknown identities, is essential. Foragers should consult experts or use reliable field guides to ensure safe identification. In regions where toxic mushrooms are prevalent, public health campaigns can raise awareness and reduce accidental ingestion. For those who experience symptoms after mushroom consumption, immediate medical evaluation is critical to prevent long-term complications and ensure effective treatment.
Mushroom Coffee and Gas: Unraveling the Digestive Effects of This Trend
You may want to see also
Frequently asked questions
While rare, certain mushrooms, especially wild varieties, may contain toxins or irritants that could potentially trigger bladder spasms in sensitive individuals.
Some wild mushrooms, like those containing toxins (e.g., Amanita species), may cause gastrointestinal distress or systemic reactions that could indirectly lead to bladder spasms.
Allergic reactions to mushrooms typically involve symptoms like itching, swelling, or digestive issues, but bladder spasms are not a common symptom of mushroom allergies.
Cooking mushrooms generally reduces the risk of adverse reactions, but if the mushrooms are toxic or an individual is sensitive, cooked mushrooms could still potentially cause issues, including bladder spasms.
If you have a history of bladder spasms, it’s best to monitor your diet and avoid foods that trigger symptoms. While mushrooms are not a common cause, consult a healthcare provider if you suspect they are contributing to your symptoms.